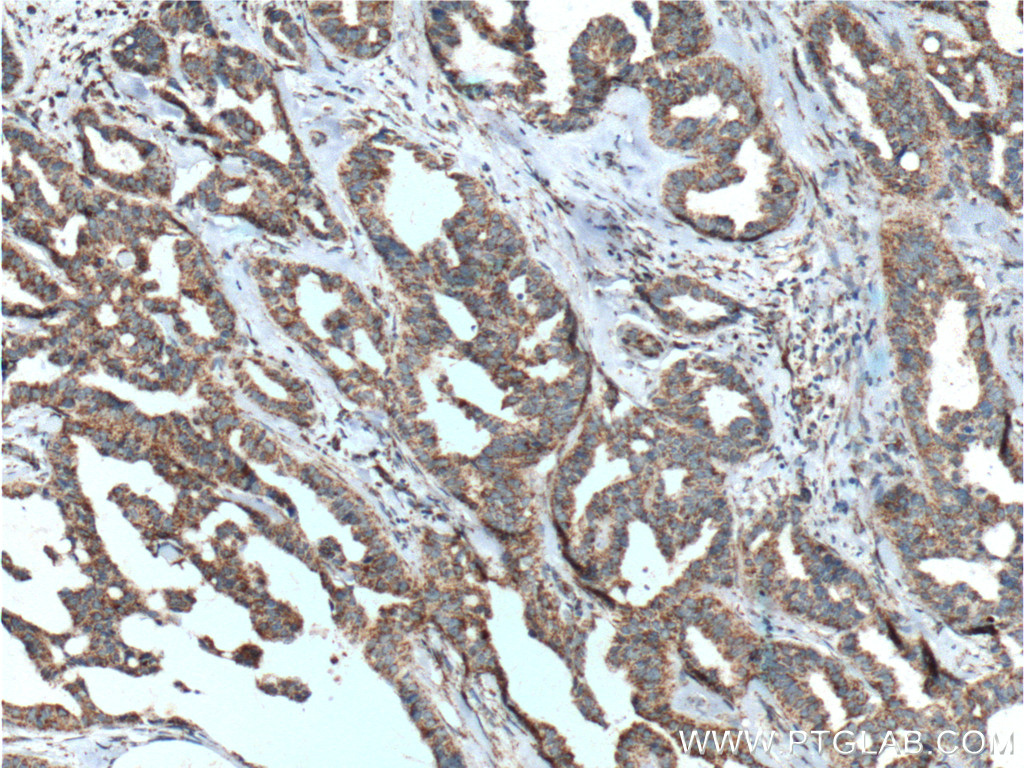

验证数据展示
经过测试的应用
| Positive WB detected in | HT-29 cells, DU 145 cells, human placenta tissue, MCF-7 cells, PC-3 cells, Hela cells |
| Positive IHC detected in | human prostate cancer tissue, human breast cancer tissue Note: suggested antigen retrieval with TE buffer pH 9.0; (*) Alternatively, antigen retrieval may be performed with citrate buffer pH 6.0 |
推荐稀释比
| 应用 | 推荐稀释比 |
|---|---|
| Western Blot (WB) | WB : 1:2000-1:16000 |
| Immunohistochemistry (IHC) | IHC : 1:50-1:500 |
| It is recommended that this reagent should be titrated in each testing system to obtain optimal results. | |
| Sample-dependent, Check data in validation data gallery. | |
发表文章中的应用
| KD/KO | See 1 publications below |
| WB | See 4 publications below |
| IHC | See 1 publications below |
产品信息
27159-1-AP targets TBXA2R in WB, IHC, ELISA applications and shows reactivity with human, mouse samples.
| 经测试应用 | WB, IHC, ELISA Application Description |
| 文献引用应用 | WB, IHC |
| 经测试反应性 | human, mouse |
| 文献引用反应性 | human, mouse, rat |
| 免疫原 |
CatNo: Ag25670 Product name: Recombinant human TBXA2R protein Source: e coli.-derived, PGEX-4T Tag: GST Domain: 1-106 aa of BC074750 Sequence: MWPNGSSLGPCFRPTNITLEERRLIASPWFAASFCVVGLASNLLALSVLAGARQGGSHTRSSFLTFLCGLVLTDFLGLLVTGTIVVSQHAALFEWHAVDPGCRLCR 种属同源性预测 |
| 宿主/亚型 | Rabbit / IgG |
| 抗体类别 | Polyclonal |
| 产品类型 | Antibody |
| 全称 | thromboxane A2 receptor |
| 别名 | Prostanoid TP receptor, TBXA2R, thromboxane A2 receptor, TP, TXA2 R |
| 计算分子量 | 343aa,37 kDa; 1043aa,113 kDa |
| 观测分子量 | 50-60 kDa |
| GenBank蛋白编号 | BC074750 |
| 基因名称 | TBXA2R |
| Gene ID (NCBI) | 6915 |
| RRID | AB_2880782 |
| 偶联类型 | Unconjugated |
| 形式 | Liquid |
| 纯化方式 | Antigen affinity purification |
| UNIPROT ID | P21731 |
| 储存缓冲液 | PBS with 0.02% sodium azide and 50% glycerol, pH 7.3. |
| 储存条件 | Store at -20°C. Stable for one year after shipment. Aliquoting is unnecessary for -20oC storage. |
背景介绍
TBXA2R, also named as thromboxane A2 receptor, TXA2-R and Prostanoid TP receptor, belongs to G-protein coupled receptor 1 family. Thromboxane A2 receptor is a key molecule in hemostasis as its abnormality leads to bleeding disorders. The TXA2-R receptor is linked via a guanine nucleotide-binding protein (G protein) to phospholipase C (PLC), which hydrolyses phosphoinositides to the two potent stimulatory second messengers inositol 1,4,5-triphosphate (IP3) and diacylglycerol. IP3 causes increases in cytoplasmic free calcium and diacylglycerol causes activation of protein kinase C. In the kidney, the binding of TXA2-R to glomerular TP receptors causes intense vasoconstriction. The two isoforms expressed in cultured cells show similar ligand binding characteristics and phospholipase C (PLC) activation but oppositely regulate adenylyl cyclase activity (PMID: 8613548).
实验方案
| Product Specific Protocols | |
|---|---|
| IHC protocol for TBXA2R antibody 27159-1-AP | Download protocol |
| WB protocol for TBXA2R antibody 27159-1-AP | Download protocol |
| Standard Protocols | |
|---|---|
| Click here to view our Standard Protocols |
发表文章
| Species | Application | Title |
|---|---|---|
Am J Respir Crit Care Med Thromboxane-Prostanoid Receptor Signaling Drives Persistent Fibroblast Activation in Pulmonary Fibrosis
| ||
Front Endocrinol (Lausanne) The Arachidonic Acid Metabolism Mechanism Based on UPLC-MS/MS Metabolomics in Recurrent Spontaneous Abortion Rats. | ||
Eur J Pharmacol Resveratrol attenuates cyclosporin A-induced upregulation of the thromboxane A2 receptor and hypertension via the AMPK/SIRT1 and MAPK/NF-κB pathways in the rat mesenteric artery | ||
Arch Dermatol Res The effect of selinexor on prostaglandin synthesis in virus-positive Merkel cell carcinoma cell lines | ||
Int J Biol Macromol Curcumin-loaded platelets with hydroxypropyl chitin hydrogel composite system through photo-activation for effective hemostasis management and wound healing |